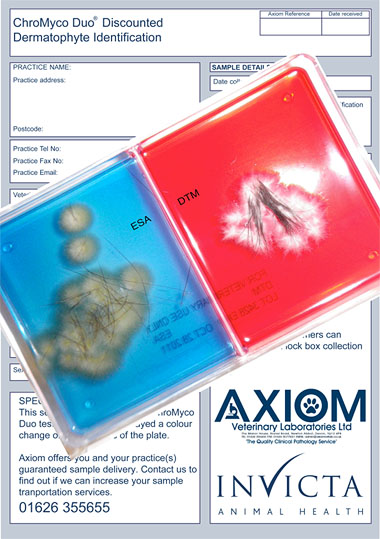
Pack shot with details sheet

Invicta In Partnership With Axiom Launches New Identification Service For ChroMyco Duo® Dermatophyte Kits
 14 years ago
14 years ago  3810 views
3810 views
Posted
27th July, 2012 15h54
Veterinary practices can now send positive ChroMyco plates to Axiom and receive a species identification report for the specially discounted price of £8.00.
Rob Watkins, Managing Director of Invicta Animal Health said, “We are delighted to launch this service in response to customer feedback. This enables practices to gain a positive dermatophyte diagnosis in as little as three to six days so that treatment can be commenced promptly. Then, by sending the plate to Axiom, the actual species can be subsequently identified.
Axiom, with its innovative microbiology department and dedication to quality combined with its reliable network of courier services and postal processing systems are the ideal Laboratory to provide this service”.
Submission forms are available free of charge from Invicta Animal Health 01403 791313. ChroMyco Duo dermatophyte test kits are available from wholesalers and priced at £25.00 for 5 kits.
For more information contact:
Rob Watkins
Managing Director
Invicta Animal Health
Phone: 01403 791313
Mobile: 07789 776269
[email protected]
Veterinary practices can now send positive ChroMyco plates to Axiom and receive a species identification report for the specially discounted price of £8.00.
Rob Watkins, Managing Director of Invicta Animal Health said, “We are delighted to launch this service in response to customer feedback. This enables practices to gain a positive dermatophyte diagnosis in as little as three to six days so that treatment can be commenced promptly. Then, by sending the plate to Axiom, the actual species can be subsequently identified.
Axiom, with its innovative microbiology department and dedication to quality combined with its reliable network of courier services and postal processing systems are the ideal Laboratory to provide this service”.
Submission forms are available free of charge from Invicta Animal Health 01403 791313. ChroMyco Duo dermatophyte test kits are available from wholesalers and priced at £25.00 for 5 kits.
For more information contact:
Rob Watkins
Managing Director
Invicta Animal Health
Phone: 01403 791313
Mobile: 07789 776269
[email protected]More from
- Ronda.vet links locum shifts to CPD rewards in UK veterinary first
- Cancellations have been damaging locum work for years but no-one was keeping count - now Ronda is
- Vet-founded charity looking to support talented youngsters
- Virbac Confirms Immediate UK Availability of Syvazul BTV 8 Vaccine for Livestock Protection
- Oxford veterinary practice unleashes its full potential with major expansion to celebrate 20th anniversary
